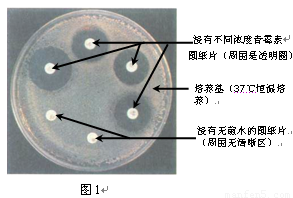
太阳成tyc7111cc官网

更新时间:2025-12-19 23:37:03 浏览: 次
本文摘要:5月22日,钟山县县委常委、政法委书记邱学斌了解石龙镇综治办、派出所调研五谷丰登建设指导工作,细心查看石龙镇的综治中心和社区戒毒(康复)工作室建设情况,并且在政府二楼会议室展开座谈交流。

5月22日,钟山县县委常委、政法委书记邱学斌了解石龙镇综治办、派出所调研五谷丰登建设指导工作,细心查看石龙镇的综治中心和社区戒毒(康复)工作室建设情况,并且在政府二楼会议室展开座谈交流。石龙镇党委领导、镇人大领导,镇综治办、派出所、司法所负责人参会列席。
座谈会上,石龙镇派出所负责人汇报了辖区基本情况、当前治安形势、压制邪教、“双提高”等各项公安工作。镇人大主席汇报了本镇的社会治安综合治理和上访维稳工作近期积极开展的情况。 在严肃征询涉及人员的工作情况汇报后,邱学斌对石龙镇在确保地方平稳、服务群众、压制邪教、五谷丰登建设等方面获得的工作成绩回应认同,同时,他做出三点命令:一是强化宣传,对对立纠纷精准排查、精准消弭。压制违法犯罪不道德,强化措施,学会做到群众工作,从源头上化解矛盾,增加涉法上访问题,规范执法人员,竖立较好的执法人员形象,提升执法人员公信力。

二是强化治安管控,融合反腐除魔压制的积极开展,压制邪教,要更进一步增强危机意识,增强群防群治,出有重拳压制邪教组织。三是强化侦察,尤其是派出所要强化群众安全感,晚上警车常常到各村侦察。邱学斌拒绝,该镇要按照坚决发展与维稳锐意,主动创意工作,将五谷丰登建设各项任务研究实施;要融合党的群众路线教育实践中活动,坚实前进引人注目治安问题排查整治、疑难上访案件消弭、农村社区网格化管理、涉法涉诉信访工作改革等与群众利益息息相关的重点工作,确保辖区平稳,提高群众安全感;要抓好基层派出所、司法所仅有覆盖面积筹划,扩充基层五谷丰登队伍,筑城哀五谷丰登根基。

本文关键词:太阳成tyc7111cc,tyc7111cc太阳成集团,太阳成tyc7111cc官网
本文来源:太阳成tyc7111cc-www.longze-gj.com




行业新闻